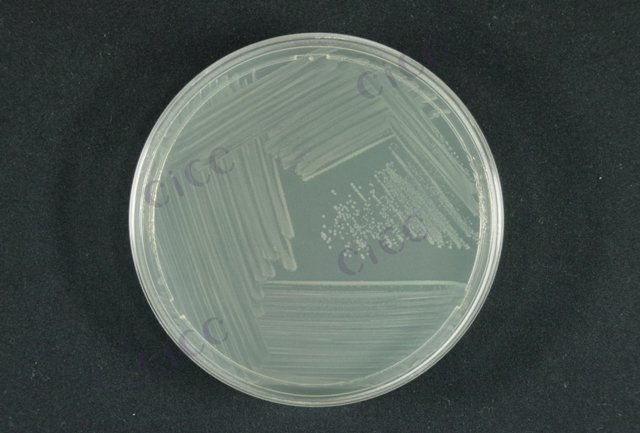
产志贺毒素大肠埃希氏菌 Escherichia coli STEC CICC 10670 Escherichia coli STEC

产志贺毒素大肠埃希氏菌 Escherichia coli STEC CICC 10670 Escherichia coli STEC
-
产志贺毒素大肠埃希氏菌 Escherichia coli STEC CICC 10668 Escherichia coli STEC
CICC 10668 | 见证书
-
产志贺毒素大肠埃希氏菌 Escherichia coli STEC CICC 10669 Escherichia coli STEC
CICC 10669 | 见证书
-
志贺毒性大肠埃希氏菌 Escherichia coli STEC
BNCC186739 | 冻干粉;斜面;菌液;平板
-
志贺毒性大肠埃希氏菌 Escherichia coli STEC
BNCC186738 | 冻干粉;斜面;菌液;平板
-
志贺毒性大肠埃希氏菌DNA标准品 Escherichia coli STEC DNA standard
BNCC377579 | 冻存管;(9.0±1.8)×10^5copies/mL;单管
-
志贺毒性大肠埃希氏菌DNA标准品 Escherichia coli STEC DNA standard
BNCC377580 | 冻存管
-
志贺毒性大肠埃希氏菌DNA标准品 Escherichia coli STEC DNA standard
BNCC377578 | 冻存管

说明书下载: 菌种说明书 打管说明书
您正在浏览的产品:产志贺毒素大肠埃希氏菌 Escherichia coli STEC CICC 10670
手机版:产志贺毒素大肠埃希氏菌 Escherichia coli STEC CICC 10670
本公司销售的所有产品仅供实验科研使用,不用于人体及临床诊断。
2. 初筛检测:通过实时荧光定量PCR技术检测毒力基因stx进行初筛[2]
3. 分离培养:阳性样本经酸处理及免疫磁珠富集后,在STEC显色培养基上进行选择性分离[2][7]
2. 核酸提取:取增菌液离心后提取DNA用于PCR检测[2]
3. 免疫磁珠富集:阳性样本经pH2.5酸性处理1小时后,使用特异性磁珠富集目标菌[7]
4. 确证实验:对分离菌株进行生化鉴定及毒力基因复核[2]
2. 显色培养基需每批次验证选择性,避免杂菌干扰[7]
3. 实时荧光PCR检测需设置内参基因(如uidA)监控扩增有效性[2]
以上信息仅供参考,请以相应标准的原文为准!